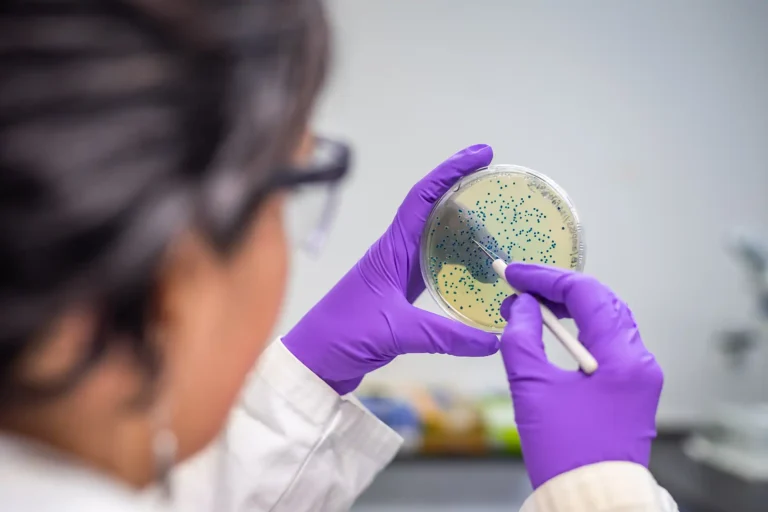

Fruškogorska 35/80
21000 Novi Sad
Srbija

ISO 35001 – Upravljanje biorizicima za laboratorije i druge srodne kompanije
Šta je ISO 35001? Sistematski pristup za identifikaciju, procenu, kontrolu i praćenje rizika biološke bezbednosti i…
Šta je ISO 35001? Sistematski pristup za identifikaciju, procenu, kontrolu i praćenje rizika biološke bezbednosti i…

Šta je ISO 19650? Informaciono modeliranje objekata (Building information modeling) je transformacija podataka u informacije, čime…

Šta je standard PAS 2050? Klimatske promene neće nestati, ali postoji pozitivna strana – sve više…

Šta je EN 1090? Standard EN 1090 utvrđuje zahteve za ocenjivanje usaglašenosti karakteristika proizvoda za konstrukcijske…

Šta je BRC Packaging standard? BRC Packaging standard razvio je British Retail Consortium, kompanija koja predstavlja…

Šta je IATF 16949? IATF 16949 je standard koji utvrđuje zahteve za sistem upravljanja kvalitetom (QMS),…

Šta je ISO 27701? ISO 27701 je međunarodni standard koji pruža smernice za upravljanje informacijama o…